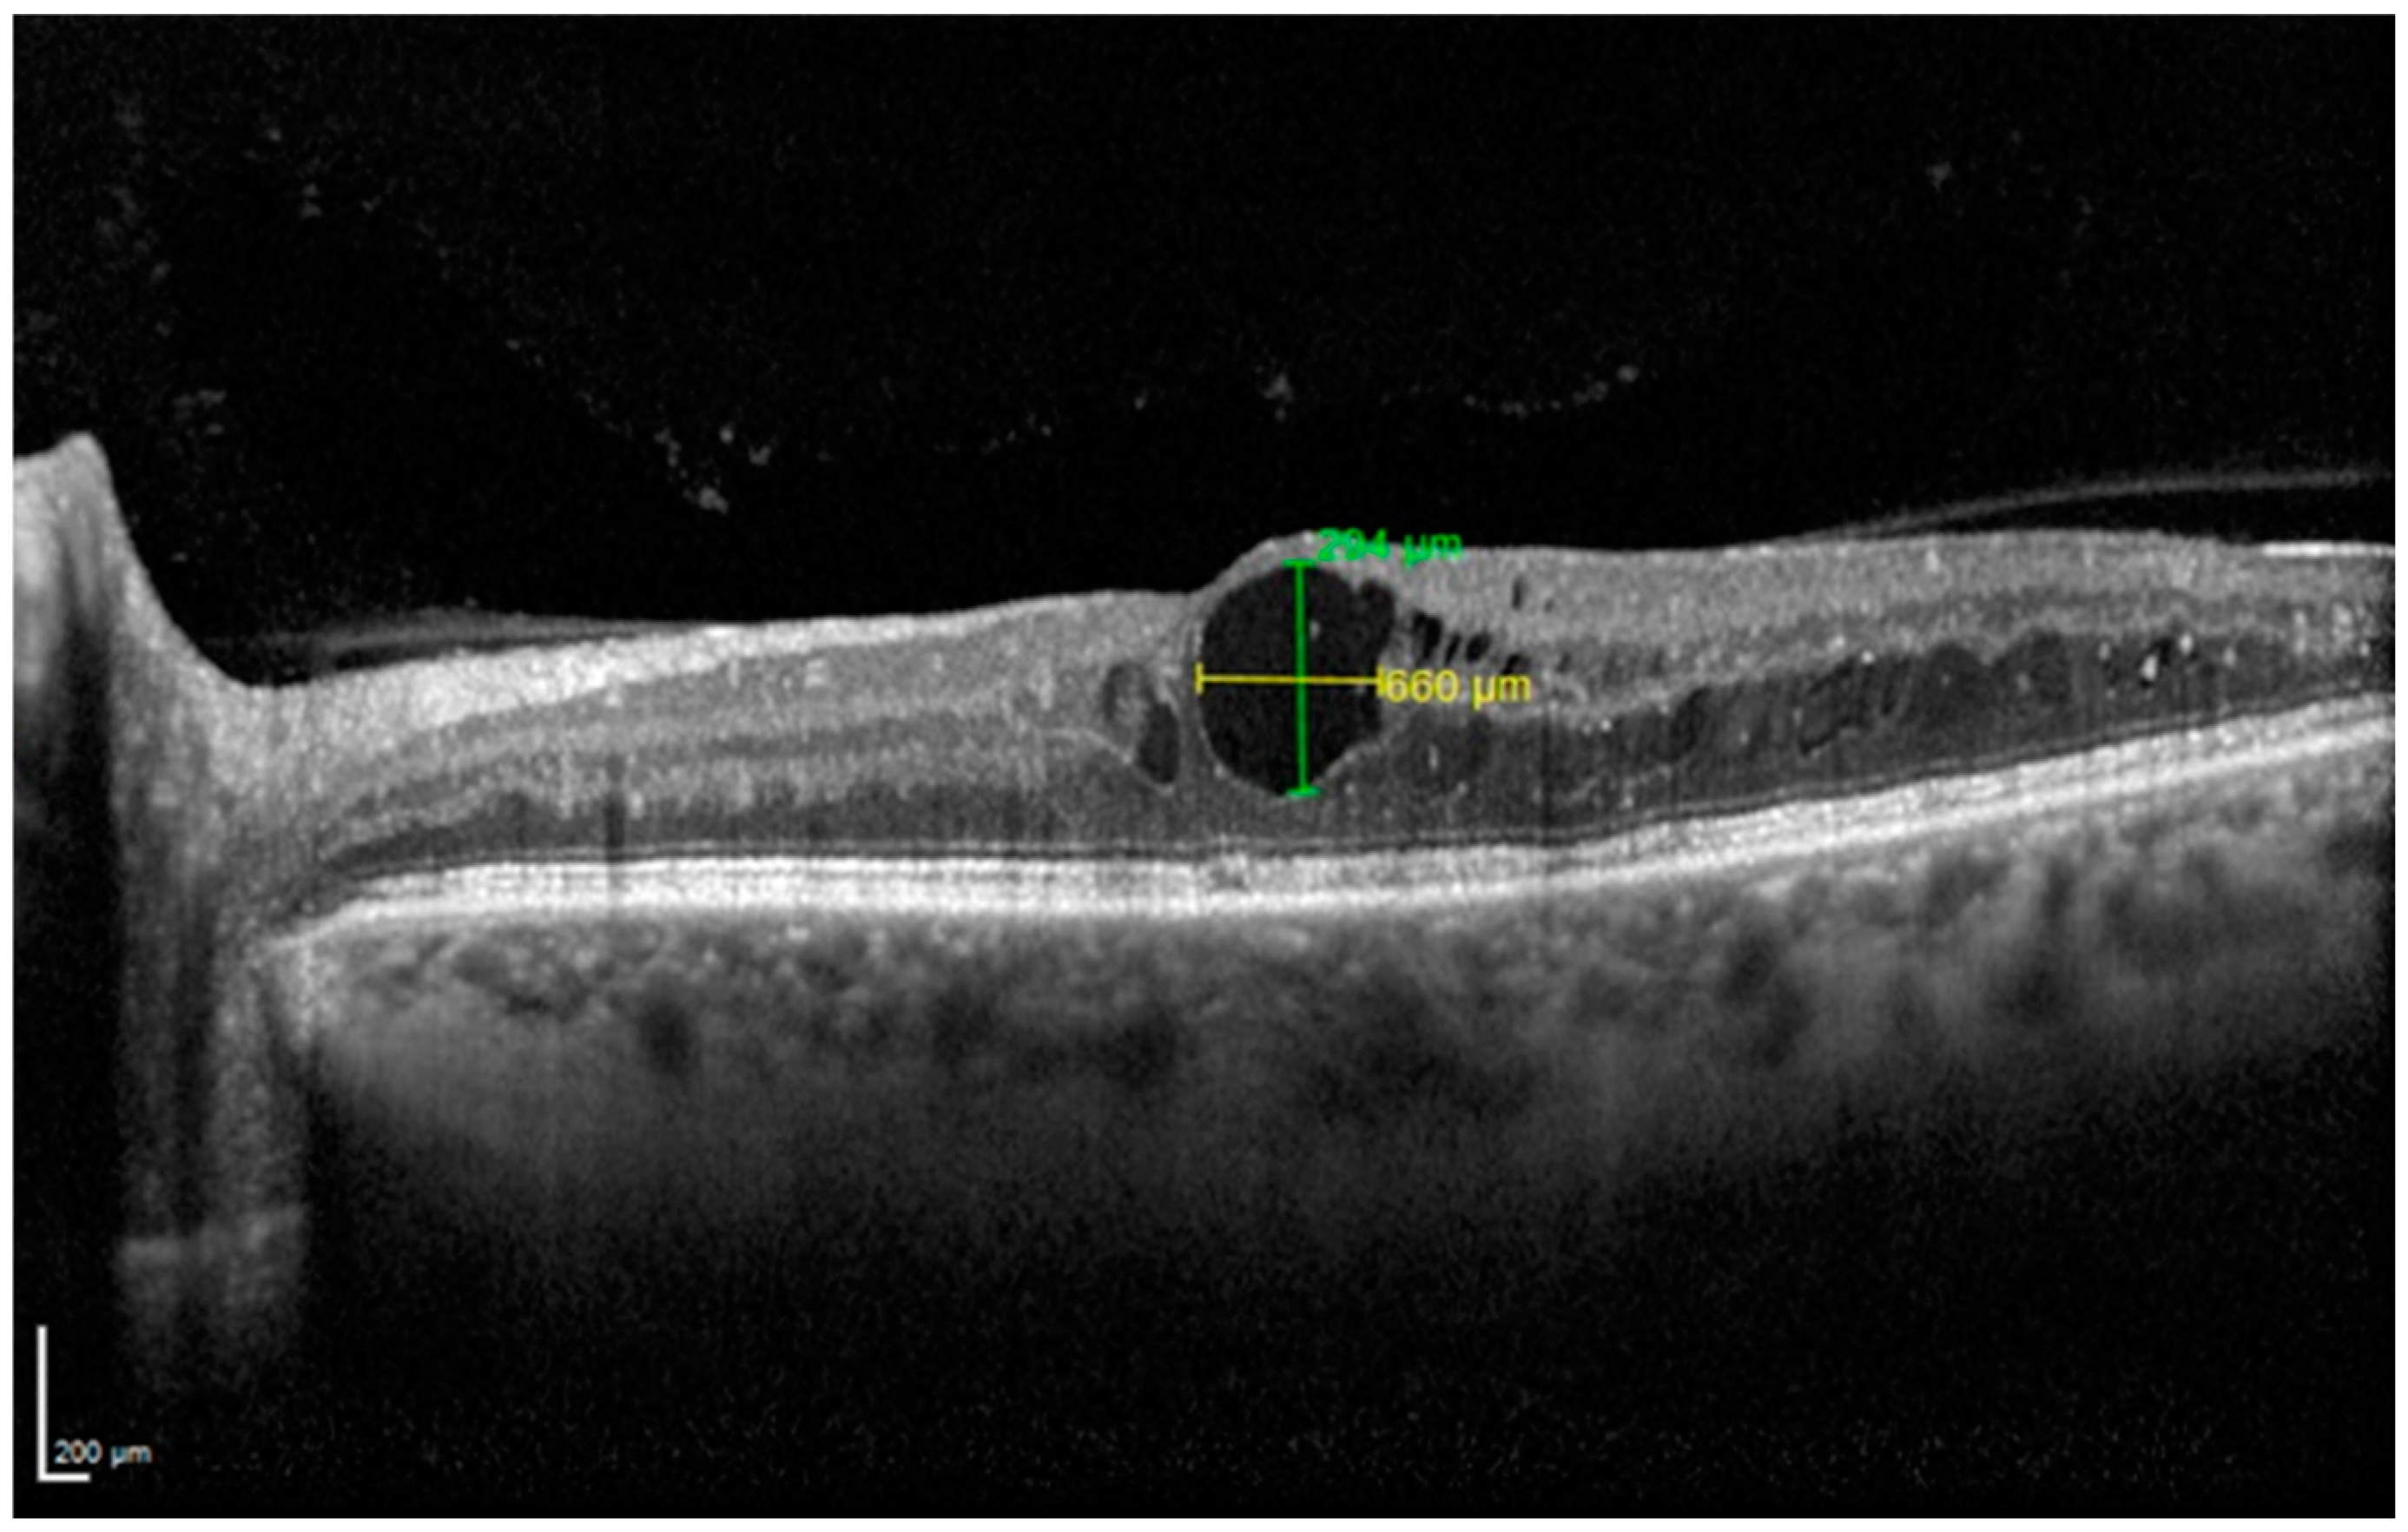
Diagnostics 14 02858 g001
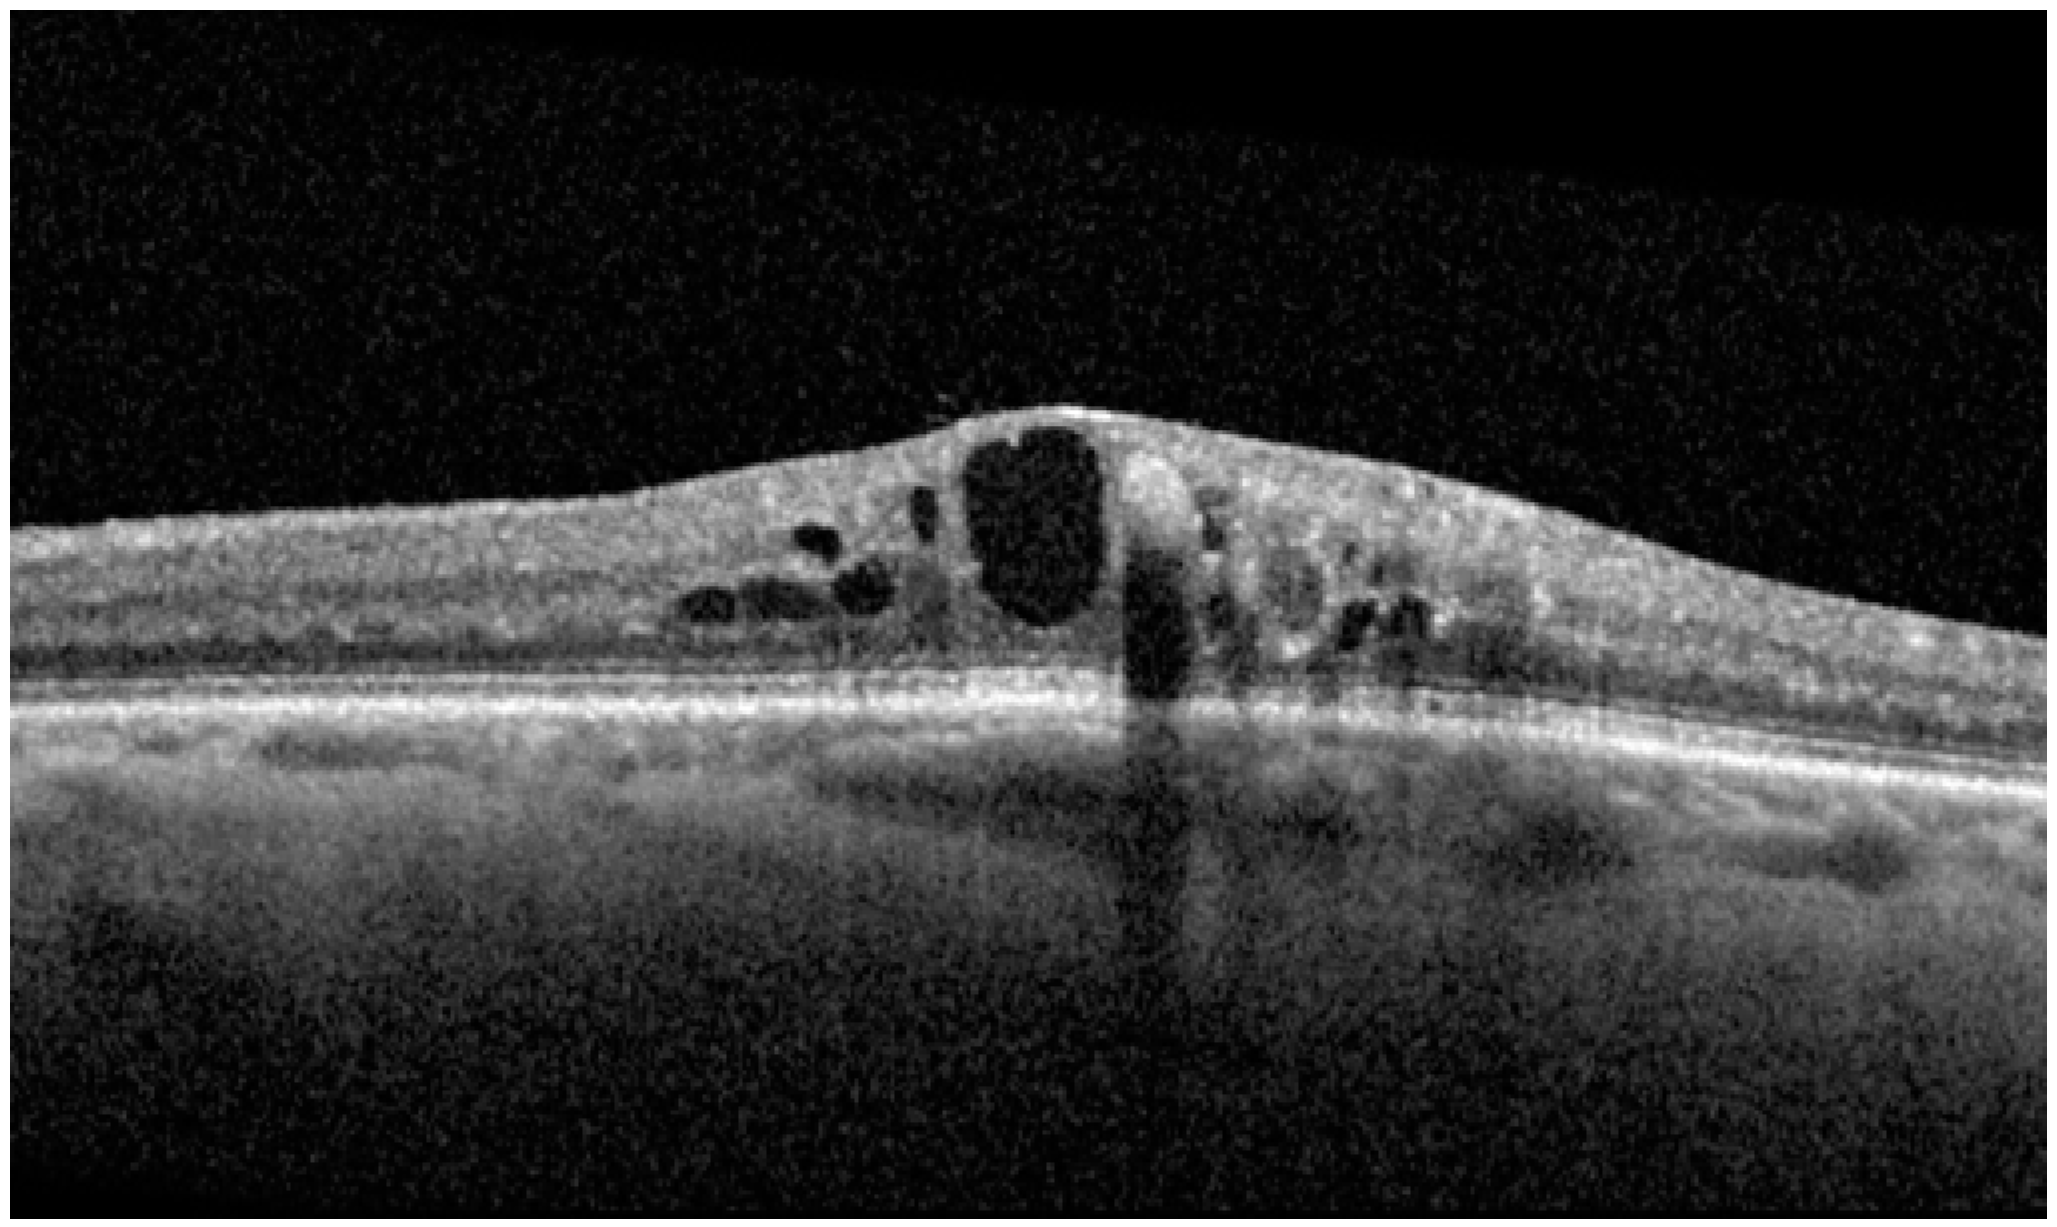
Diagnostics 14 02858 g006

Brolucizumab for the Treatment of Diabetic Macular Edema: An Optical Coherence Tomography-Based Analysis
Abstract
1. Introduction
2. Materials and Methods
3. Results
4. Discussion
5. Conclusions
Author Contributions
Funding
Institutional Review Board Statement
Informed Consent Statement
Data Availability Statement
Conflicts of Interest
References
- Virgili, G.; Parravano, M.; Evans, J.R.; Gordon, I.; Lucenteforte, E. Anti-vascular endothelial growth factor for diabetic macular oedema: A network meta-analysis. Cochrane Database Syst. Rev. 2018, 2018, CD007419. [Google Scholar] [CrossRef]
- Nozaki, M.; Ando, R.; Kimura, T.; Kato, F.; Yasukawa, T. The Role of Laser Photocoagulation in Treating Diabetic Macular Edema in the Era of Intravitreal Drug Administration: A Descriptive Review. Medicina 2023, 59, 1319. [Google Scholar] [CrossRef]
- Dugel, P.U.; Koh, A.; Ogura, Y.; Jaffe, G.J.; Schmidt-Erfurth, U.; Brown, D.M.; Andre, V.; Warburton, J.; Weichselberger, A.; Holz, F.G.; et al. HAWK and HARRIER: Phase 3, Multicenter, Randomized, Double-Masked Trials of Brolucizumab for Neovascular Age-Related Macular Degeneration. Ophthalmology 2020, 127, 72–84. [Google Scholar] [CrossRef]
- Brown, D.M.; Emanuelli, A.; Bandello, F.; Barranco, J.J.E.; Figueira, J.; Souied, E.; Wolf, S.; Gupta, V.; Ngah, N.F.; Liew, G.; et al. KESTREL and KITE: 52-Week Results from Two Phase III Pivotal Trials of Brolucizumab for Diabetic Macular Edema. Am. J. Ophthalmol. 2022, 238, 157–172. [Google Scholar] [CrossRef] [PubMed]
- Huang, D.; Swanson, E.A.; Lin, C.P.; Schuman, J.S.; Stinson, W.G.; Chang, W.; Hee, M.R.; Flotte, T.; Gregory, K.; Puliafito, C.A.; et al. Optical coherence tomography. Science 1991, 254, 1178–1181. [Google Scholar] [CrossRef] [PubMed] [PubMed Central]
- Panozzo, G.; Cicinelli, M.V.; Augustin, A.J.; Parodi, M.B.; Cunha-Vaz, J.; Guarnaccia, G.; Kodjikian, L.; Jampol, L.M.; Jünemann, A.; Lanzetta, P.; et al. An optical coherence tomography-based grading of diabetic maculopathy proposed by an international expert panel: The European School for Advanced Studies in Ophthalmology classification. Eur. J. Ophthalmol. 2020, 30, 8–18. [Google Scholar] [CrossRef]
- Madjedi, K.; Pereira, A.; Ballios, B.G.; Arjmand, P.; Kertes, P.J.; Brent, M.; Yan, P. Switching between anti-VEGF agents in the management of refractory diabetic macular edema: A systematic review. Surv. Ophthalmol. 2022, 67, 1364–1372. [Google Scholar] [CrossRef] [PubMed]
- Chen, X.; Zhu, W.; Li, X. OCT Macular Volume as a Predictor of Vascular Leakage in Uveitis. Ophthalmol. Ther. 2022, 11, 1913–1924. [Google Scholar] [CrossRef] [PubMed]
- McGahren, W.J.; Van den Hende, J.H.; Mitscher, L.A. Chlorinated cyclopentenone fungitoxic metabolites from the fungus, Sporormia affinis. J. Am. Chem. Soc. 1969, 91, 157–162. [Google Scholar] [CrossRef] [PubMed]
- Gaucher, D.; Sebah, C.; Erginay, A.; Haouchine, B.; Tadayoni, R.; Gaudric, A.; Massin, P. Optical coherence tomography features during the evolution of serous retinal detachment in patients with diabetic macular edema. Am. J. Ophthalmol. 2008, 145, 289–296. [Google Scholar] [CrossRef]
- Alaupovic, P. Use of apolipoprotein parameters and endpoints in drug development and approval processes. Am. J. Cardiol. 1998, 81, 40F–47F. [Google Scholar] [CrossRef] [PubMed]
- Schneider, C.A.; Rasband, W.S.; Eliceiri, K.W. NIH Image to ImageJ: 25 years of image analysis. Nat. Methods 2012, 9, 671–675. [Google Scholar] [CrossRef]
- Vujosevic, S.; Toma, C.; Villani, E.; Muraca, A.; Torti, E.; Florimbi, G.; Leporati, F.; Brambilla, M.; De Cilla, S. Diabetic macular edema with neuroretinal detachment: OCT and OCT-angiography biomarkers of treatment response to anti-VEGF and steroids. Acta Diabetol. 2020, 57, 287–296. [Google Scholar] [CrossRef]
- Braham, I.Z.; Kaouel, H.; Boukari, M.; Ammous, I.; Errais, K.; Boussen, I.M.; Zhioua, R. Optical coherence tomography angiography analysis of microvascular abnormalities and vessel density in treatment-naïve eyes with diabetic macular edema. BMC Ophthalmol. 2022, 22, 418. [Google Scholar] [CrossRef]
- Pastore, M.R.; Milan, S.; Cirigliano, G.; Tognetto, D. Functional and anatomical outcomes of brolucizumab for nAMD in a real-life setting. Sci. Rep. 2024, 14, 1441. [Google Scholar] [CrossRef]
- Hirano, T.; Kumazaki, A.; Tomihara, R.; Ito, S.; Hoshiyama, K.; Murata, T. Evaluating initial responses to brolucizumab in patients undergoing conventional anti-VEGF therapy for diabetic macular edema: A retrospective, single-center, observational study. Sci. Rep. 2023, 13, 10901. [Google Scholar] [CrossRef] [PubMed]
- Murray, J.E.; Gold, A.S.; Latiff, A.; Murray, T.G. Brolucizumab: Evaluation of Compassionate Use of a Complex Anti-VEGF Therapy. Clin. Ophthalmol. 2021, 15, 4731–4738. [Google Scholar] [CrossRef]
- Kulikov, A.; Malafeeva, A.; Kalinicheva, Y.; Maltsev, D.; Zhalimova, V.; Vasilyev, A. Short-term experience of intravitreal brolucizumab in treatment of diabetic macular edema. Vestn. Oftalmol. 2023, 139, 99–105. [Google Scholar] [CrossRef] [PubMed]
- Chakraborty, D.; Mondal, S.; Parachuri, N.; Kumar, N.; Sharma, A. Brolucizumab-early experience with early extended interval regime in chronic centre involved diabetic macular oedema. Eye 2022, 36, 358–360. [Google Scholar] [CrossRef] [PubMed]
- Hua, R.; Liu, L.; Wang, X.; Chen, L. Imaging evidence of diabetic choroidopathy in vivo: Angiographic pathoanatomy and choroidal-enhanced depth imaging. PLoS ONE 2013, 8, e83494. [Google Scholar] [CrossRef] [PubMed]
- Kim, J.T.; Lee, D.H.; Joe, S.G.; Kim, J.-G.; Yoon, Y.H. Changes in choroidal thickness in relation to the severity of retinopathy and macular edema in type 2 diabetic patients. Investig. Ophthalmol. Vis. Sci. 2013, 54, 3378–3384. [Google Scholar] [CrossRef]
- Rewbury, R.; Want, A.; Varughese, R.; Chong, V. Subfoveal choroidal thickness in patients with diabetic retinopathy and diabetic macular oedema. Eye 2016, 30, 1568–1572. [Google Scholar] [CrossRef] [PubMed]
- Gupta, C.; Tan, R.; Mishra, C.; Khandelwal, N.; Raman, R.; Kim, R.; Agrawal, R.; Sen, P. Choroidal structural analysis in eyes with diabetic retinopathy and diabetic macular edema-A novel OCT based imaging biomarker. PLoS ONE 2018, 13, e0207435. [Google Scholar] [CrossRef] [PubMed]
- Vujosevic, S.; Toma, C.; Villani, E.; Muraca, A.; Torti, E.; Florimbi, G.; Leporati, F.; Brambilla, M.; De Cilla, S. Three-dimensional automated choroidal volume assessment on standard spectral-domain optical coherence tomography and correlation with the level of diabetic macular edema. Am. J. Ophthalmol. 2014, 158, 1039–1048. [Google Scholar]
- Kniggendorf, V.F.; Novais, E.A.; Kniggendorf, S.L.; Xavier, C.; Cole, E.D.; Regatieri, C.V. Effect of intravitreal anti-VEGF on choroidal thickness in patients with diabetic macular edema using spectral domain OCT. Arq. Bras. Oftalmol. 2016, 79, 155–158. [Google Scholar] [CrossRef]
- Udaondo Mirete, P.; Muñoz-Morata, C.; Albarrán-Diego, C.; España-Gregori, E. Influence of Intravitreal Therapy on Choroidal Thickness in Patients with Diabetic Macular Edema. J. Clin. Med. 2023, 12, 348. [Google Scholar] [CrossRef]
- Tamashiro, T.; Tanaka, K.; Itagaki, K.; Nakayama, M.; Maruko, I.; Wakugawa, S.; Terao, N.; Onoe, H.; Wakatsuki, Y.; Ogasawara, M.; et al. Subfoveal choroidal thickness after brolucizumab therapy for neovascular age-related macular degeneration: A short-term multicenter study. Graefes Arch. Clin. Exp. Ophthalmol. 2022, 260, 1857–1865. [Google Scholar] [CrossRef] [PubMed]
- Vujosevic, S.; Torresin, T.; Bini, S.; Convento, E.; Pilotto, E.; Parrozzani, R.; Midena, E. Imaging retinal inflammatory biomarkers after intravitreal steroid and anti-VEGF treatment in diabetic macular oedema. Acta Ophthalmol. 2017, 95, 464–471. [Google Scholar] [CrossRef] [PubMed]
- Szeto, S.K.; Hui, V.W.K.; Tang, F.Y.; Yang, D.; Sun, Z.H.; Mohamed, S.; Chan, C.K.M.; Lai, T.Y.Y.; Cheung, C. OCT-based biomarkers for predicting treatment response in eyes with centre-involved diabetic macular oedema treated with anti-VEGF injections: A real-life retina clinic-based study. Br. J. Ophthalmol. 2023, 107, 525–533. [Google Scholar] [CrossRef] [PubMed]
- Hwang, D.D.J. Optical Coherence Tomography Reflectivity in Foveal Cysts: A Novel Biomarker for Early-Response Prediction of Diabetic Macular Edema Treated with Dexamethasone. Life 2022, 12, 1475. [Google Scholar] [CrossRef]
- Karahan, E.; Kayikcioglu, O.C.; Vural, G.S.; Guler, C. Predictive value of the characteristics of intraretinal cystoid spaces on early response to antivascular endothelial growth factor treatment in patients with cystoid diabetic macular edema. Arq. Bras. Oftalmol. 2022, 86, e2021-0462. [Google Scholar] [CrossRef] [PubMed]

| Demographic Data | Results |
|---|---|
| Number of eyes (patients) | 28 (28) |
| Sex (male/female) | 16:12 |
| Age (years), mean ± SD * | 69.31 ± 7.63 |
| Mean diabetes duration (years), mean ± SD * | 21.2 ± 9.09 |
| Diabetes type (1:2) | 4:24 |
| Insulin-dependent (yes/no) | 18:10 |
| Last HbA1c (%), mean ± SD * | 7.01 ± 0.71 |
| Metabolic decompensation within the last year | 0 |
| Proliferative diabetic retinopathy (not active), n of patients | 4 |
| Previous intravitreal anti-VEGF †: number of patients | 28 |
| Previous intravitreal anti-VEGF †: number of injections (mean ± SD *) | 13.3 ± 6.78 |
| Previous intravitreal steroids: number of patients | 14 |
| Previous intravitreal steroids: number of injections (mean ± SD *) | 3.88 ± 3.96 |
| Interval between the last injection of other anti-VEGF and W0 (weeks) (mean ± SD *) | 19.94 ± 12.48 |
| Week 0 | Week 6 | p (W6 vs. W0) * | Week 12 | p (W12 vs. W6) * | Week 18 | p (W18 vs. W12) * | Week 24 | p (W24 vs. W18) * | Week 30 | p (W30 vs. W24) * | |
|---|---|---|---|---|---|---|---|---|---|---|---|
| Central Subfield Thickness, µm (mean ± SD) | 496.93 ± 79.06 | 379.93 ± 116.96 | 0.0001 | 353.53 ± 116.11 | 0.0081 | 334.73 ± 111.99 | 0.0017 | 318.47 ± 99.58 | 0.0073 | 300.67 ± 84.61 | 0.0017 |
| Macular Volume, mm3 (mean ± SD) | 11.07 ± 1.47 | 9.77 ± 1.72 | 0.0089 | 9.04 ± 1.82 | 0.0682 | 9.23 ± 1.85 | 0.0365 | 9.17 ± 1.88 | 0.0247 | 8.33 ± 1.48 | 0.0114 |
| Subfoveal Choroidal Thickness, µm (mean ± SD) | 188.6 ± 84.67 | 182.07 ± 89.60 | 0.2842 | 176.40 ± 83.25 | 0.1966 | 182.33 ± 80.70 | 0.2501 | 179.20 ± 81.26 | 0.1717 | 179.20 ± 81.83 | 0.1718 |
| Baseline | After the 1st Injection | p | |
|---|---|---|---|
| FAZ * area at the SCP † (mean, mm2 ± SD ⊥) | 0.33 ± 0.18 | 0.24 ± 0.04 | 0.36 |
| FAZ * area at the DCP ** (mean, mm2 ± SD ⊥) | 0.36 ± 0.17 | 0.26 ± 0.04 | 0.27 |
| VD ‡ at the SCP † (mean, % ± SD †) | 30.30 ± 0.07 | 28.34 ± 0.06 | 0.14 |
| VD ‡ at the DCP ** (mean, % ± SD †) | 21.40 ± 0.06 | 20.36 ± 0.07 | 0.63 |
Disclaimer/Publisher’s Note: The statements, opinions and data contained in all publications are solely those of the individual author(s) and contributor(s) and not of MDPI and/or the editor(s). MDPI and/or the editor(s) disclaim responsibility for any injury to people or property resulting from any ideas, methods, instructions or products referred to in the content. |
© 2024 by the authors. Licensee MDPI, Basel, Switzerland. This article is an open access article distributed under the terms and conditions of the Creative Commons Attribution (CC BY) license (https://creativecommons.org/licenses/by/4.0/).
Share and Cite
Pastore, M.R.; Milan, S.; Gouigoux, S.; Colombo, O.; Rinaldi, S.; Cirigliano, G.; Tognetto, D. Brolucizumab for the Treatment of Diabetic Macular Edema: An Optical Coherence Tomography-Based Analysis. Diagnostics 2024, 14, 2858. https://doi.org/10.3390/diagnostics14242858
Pastore MR, Milan S, Gouigoux S, Colombo O, Rinaldi S, Cirigliano G, Tognetto D. Brolucizumab for the Treatment of Diabetic Macular Edema: An Optical Coherence Tomography-Based Analysis. Diagnostics. 2024; 14(24):2858. https://doi.org/10.3390/diagnostics14242858
Chicago/Turabian StylePastore, Marco R., Serena Milan, Stefano Gouigoux, Olimpia Colombo, Silvia Rinaldi, Gabriella Cirigliano, and Daniele Tognetto. 2024. "Brolucizumab for the Treatment of Diabetic Macular Edema: An Optical Coherence Tomography-Based Analysis" Diagnostics 14, no. 24: 2858. https://doi.org/10.3390/diagnostics14242858
APA StylePastore, M. R., Milan, S., Gouigoux, S., Colombo, O., Rinaldi, S., Cirigliano, G., & Tognetto, D. (2024). Brolucizumab for the Treatment of Diabetic Macular Edema: An Optical Coherence Tomography-Based Analysis. Diagnostics, 14(24), 2858. https://doi.org/10.3390/diagnostics14242858

